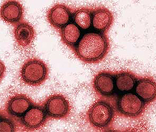

| NOTICIAS | ZK - SEPTIEMBRE 2009 |
|
VIRUS H1N1 Y LA GRIPE A miles de muertos y cientos de miles de afectados |
Keidell/ Puede que esto sea objeto de paranoia o puede que la situación esté de verdad empeorando de forma crítica. Según los informes de la OMS, la cantidad de defunciones por causa de la gripe A se aproxima a los 3.000, mientras que la cantidad de afectados supera ya los 250.000 individuos. Esto puede sonar alarmante, pero seguramente son cifras mucho menores que las reales, puesto que sólo comprenden los casos confirmados por laboratorios. Categorizando los datos según las regiones continentales, Europa ha confirmado más de 100 muertes; América sique siendo la región que ha cuenta más muertes, con más de 2200 decesos confirmados. El sureste asiático ha contabilizado casi 190 muertes, aunque las regiones del sur y sudeste muestran un incremento cada vez más notorio de esta infección. |
 "Ésta no es que sea la mejor forma de evitar contagio, pero..." |
|||
|
En África sólo se cuentan oficialmente 11 muertes, aunque el nivel de infectados es mucho más elevado, con casi 3900 personas. La OMS ha destacado que esto podría haber sido más catastrófico, pero resulta que el virus H1N1, causante de esta gripe, al parecer no ha mutado. |
Ha permanecido así desde que se descubrió, lo cual no dice que la situación vaya a seguir así. En el caso de España, los avances de esta gripe son más rápidos que el de las medidas que hay que tomar a nivel autonómico. No parece que estén muy paranoicos con esto... |
|||